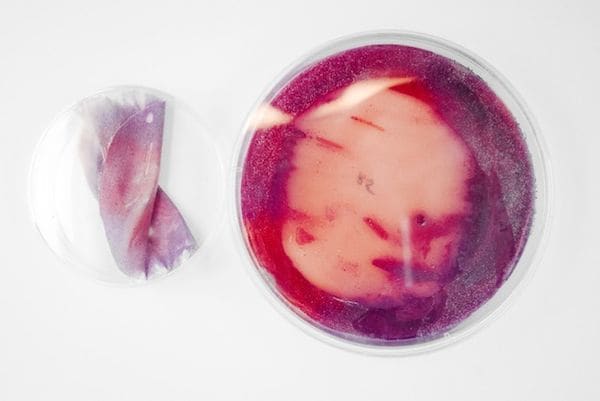

Natsai Audrey Chieza Discovered a Way to Dye Scarves with Bacteria
Alyson Wyers — April 25, 2014 — Tech
References: thisisalive & psfk
Zimbabwe born artist Natsai Audrey Chieza has discovered an engrossing new way to create ink by using bacteria. In a textile project called FABER Features, the London based designer and researcher uses dye made from soil bacteria to paint scarves. The designer discovered some bacteria taken from the roots of herbs including tarragon and sage create different colors when cultured.
Just as the colors from the bacteria ink is unique, the dye also creates unique patterns as the microbes soak in silk material. Naturally, Natsai Audrey Chieza decided to display her discovery on silk scarves. In collaboration with John Ward and the Ward Lab at UCL, FABER Features was featured in an exhibit in Paris last year called 'En Vie-Alive.'
Just as the colors from the bacteria ink is unique, the dye also creates unique patterns as the microbes soak in silk material. Naturally, Natsai Audrey Chieza decided to display her discovery on silk scarves. In collaboration with John Ward and the Ward Lab at UCL, FABER Features was featured in an exhibit in Paris last year called 'En Vie-Alive.'
Trend Themes
-
Bacteria-based Dyeing — Opportunity to disrupt the fashion industry by introducing environmentally-friendly and unique color dyeing methods using bacteria.
-
Microbial Textile Art — Innovative opportunity to combine biology and art to create one-of-a-kind microbial patterns on textiles, opening up new possibilities for artistic expression.
-
Sustainable Ink Production — Disruptive opportunity to develop alternative, eco-friendly ink production methods by harnessing bacteria cultures, reducing the environmental impact of conventional ink manufacturing.
Industry Implications
-
Fashion and Textiles — Potential to revolutionize the fashion industry by introducing sustainable and unique dyeing techniques using bacteria-based ink, offering consumers eco-friendly and aesthetically appealing options.
-
Art and Design — Opportunity to merge science and art in the creation of microbial textile patterns, providing artists and designers with a new and innovative medium for their artistic expression.
-
Printing and Ink Manufacturing — Disruptive opportunity to transform traditional ink production by leveraging bacteria cultures to create sustainable and biodegradable inks, reducing the environmental impact of the printing industry.
3.5
Score
Popularity
Activity
Freshness